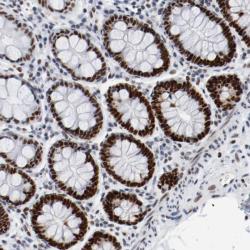

Antibody data
- Antibody Data
- Antigen structure
- References [2]
- Comments [0]
- Validations
- Western blot [1]
- Immunohistochemistry [1]
Submit
Validation data
Reference
Comment
Report error
- Product number
- sc-17776 - Provider product page

- Provider
- Santa Cruz Biotechnology
- Proper citation
- Santa Cruz Biotechnology Cat#sc-17776, RRID:AB_675487
- Product name
- Anti-POLD1
- Antibody type
- Monoclonal
- Antigen
- Recombinant full-length protein
- Reactivity
- Human
- Host
- Mouse
Submitted references Role of the ubiquitin-binding domain of Polη in Rad18-independent translesion DNA synthesis in human cell extracts.
Sequential recruitment of the repair factors during NER: the role of XPG in initiating the resynthesis step.
Schmutz V, Janel-Bintz R, Wagner J, Biard D, Shiomi N, Fuchs RP, Cordonnier AM
Nucleic acids research 2010 Oct;38(19):6456-65
Nucleic acids research 2010 Oct;38(19):6456-65
Sequential recruitment of the repair factors during NER: the role of XPG in initiating the resynthesis step.
Mocquet V, Lainé JP, Riedl T, Yajin Z, Lee MY, Egly JM
The EMBO journal 2008 Jan 9;27(1):155-67
The EMBO journal 2008 Jan 9;27(1):155-67
No comments: Submit comment
Supportive validation
- Submitted by
- per
- Main image

- Experimental details
- Western blot analysis of antibody specificity using a routine panel composed of IgG/HSA-depleted human plasma and protein lysates from selected human tissues and cell lines.
- Validation comment
- Single band corresponding to the predicted size in kDa (+/-20%).
- Primary Ab dilution
- 1:500
- Secondary Ab dilution
- 1:7000
- Lane 1
- Marker [kDa]: 230, 110, 82, 49.3, 32.2, 25.5, 17.6
- Lane 2
- RT-4
- Lane 3
- U-251MG sp
- Lane 4
- A-431
- Lane 5
- Liver
- Lane 6
- Tonsil
- Theoretical target weight
- [kDa] 126
Supportive validation
- Submitted by
- per
- Main image
- Experimental details
- Immunohistochemical staining of human colon shows strong nuclear positivity in glandular cells.
- Validation comment
- Staining pattern consistent with experimental and/or bioinformatic data.